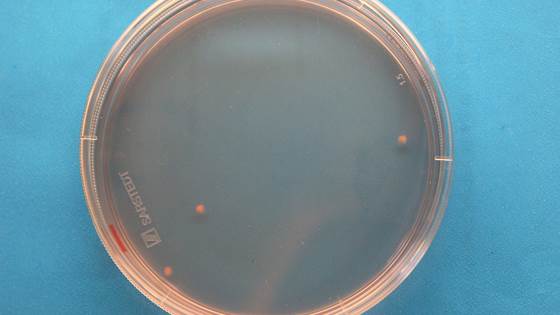

SINTEF tar klimainitiativ på FNs klimatoppmøte COP29
SINTEF legger frem rapporten "Teknologi for raskere global klimaomstilling” under årets klimatoppmøte COP29 i Aserbajdsjan.

SINTEF legger frem rapporten "Teknologi for raskere global klimaomstilling” under årets klimatoppmøte COP29 i Aserbajdsjan.

Cyberangrep, teknologisk krigføring, helserevolusjon og behov for kunstig intelligens i industrien. Forskning på fremtidens teknologi er viktigere enn noensinne.
Mange store oppdagelser og oppfinnelser springer ut fra grunnforskning. Særlig innenfor medisin, men også fra mange andre fagfelt. Her er noen av dem.

En ny ørepropp kan fungere som både hørselsvern, musikk-avspiller og mikrofon – samtidig! Sentralt i teknologien står en MEMS-brikke som SINTEF har utviklet sammen med Minuendo AS.

Er du bitt av løpebasillen? Da har du kanskje lurt på akkurat dette spørsmålet. Her får du svar.

SINTEF Digital har landet tre nye Pathfinder-prosjekter på ett år. – Veldig gledelig når vi vet at nåløyet er svært trangt, sier konserndirektør i SINTEF Digital.

Arbeidsplasser som legger til rette for god integrering av arbeidsliv og privatliv, får ansatte som trives og presterer bedre, ifølge forskning.

En kunstig «nese» fra Norge beskytter astronautene mot giftige gasser. Nå skal den til månen. Kanskje helt til Mars.

Gjennom to forskningsprosjekter skal SINTEF undersøke hvilke erfaringer verneombud og medlemmer i AMU har med HMS-opplæring. Svarene vil bidra til ny kunnskap om HMS-opplæring i norsk arbeidsliv.